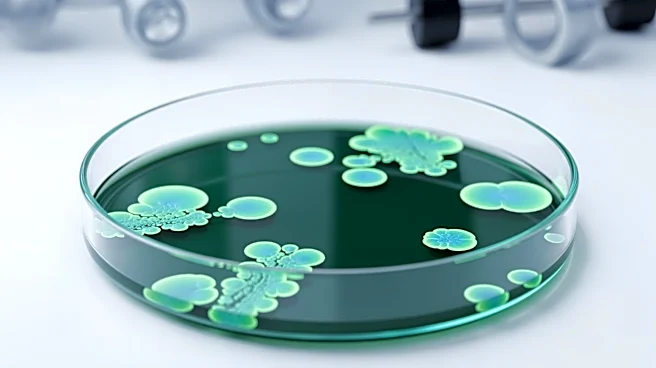

What's Happening?
A recent study published in the journal Environmental Science & Technology highlights the potential for bacteria in hospital environments to develop tolerance to antiseptics, which could contribute to antibiotic resistance. Researchers found that bacteria exposed
to low concentrations of antiseptics like chlorhexidine can survive and potentially transfer resistance genes to other bacteria. This study, conducted in an Illinois medical center's intensive care unit, revealed that 36% of bacteria samples showed tolerance to chlorhexidine. The persistence of antiseptic residues on surfaces, even after cleaning, creates environments where bacteria can evolve tolerance and resistance genes. The study emphasizes the need for antimicrobial stewardship and responsible use of antiseptics to prevent the spread of resistant bacteria.
Why It's Important?
The findings of this study are significant as they suggest that antiseptic exposure alone, without the use of antibiotics, can drive the development of antibiotic resistance. This poses a threat to public health, as resistant bacteria can lead to infections that are difficult to treat. The study underscores the importance of using antiseptics judiciously, especially in high-risk settings like hospitals, to prevent the emergence of resistant strains. The potential for bacteria to transfer resistance genes across species further complicates efforts to control antimicrobial resistance. This research calls for a reevaluation of antiseptic use policies to balance infection control with the risk of promoting resistance.
What's Next?
Further research is needed to explore the effects of antiseptic residues in other environments, such as homes and veterinary clinics, to understand their impact on bacterial resistance. The study suggests that antiseptic use should be reserved for high-risk situations, and alternative cleaning methods, like soap and water, may be sufficient in less critical settings. Policymakers and healthcare providers may need to consider revising guidelines for antiseptic use to mitigate the risk of resistance. Continued monitoring and research are essential to develop strategies that effectively manage the use of antimicrobials and prevent the spread of resistant bacteria.